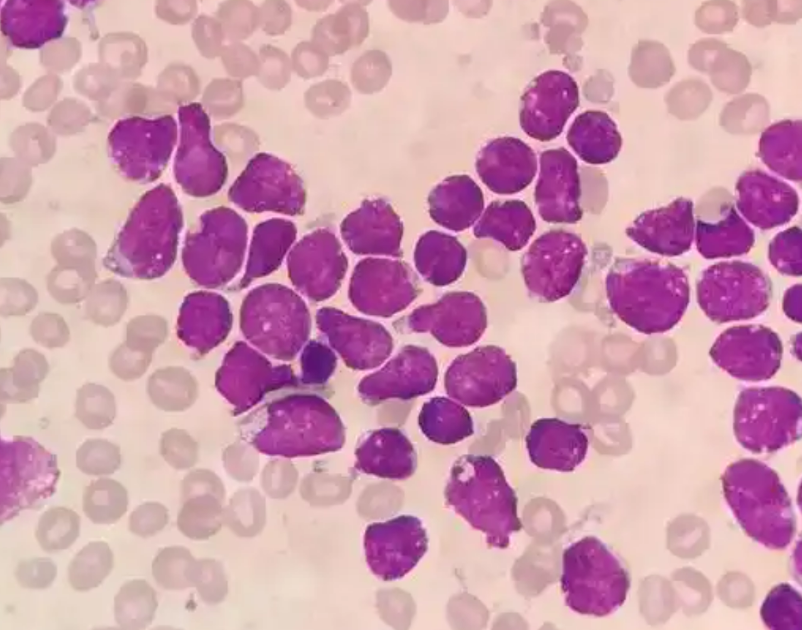

uedbet(中国)官方app 破解“慢淋”“小淋”提拔三浩劫题,中国在研改进药展现独到后劲
发布日期:2026-04-03 11:49:50 点击次数:151

在最近举行的第67届好意思国血液学会(ASH)年会上,中国原研新式口服高采纳性BCL2 扼制剂 mesutoclax提拔慢性淋巴细胞白血病/小淋巴细胞淋巴瘤(CLL/SLL)的盘问凯旋入选大会海报展示,成为中国改进药在血液肿瘤界限的亮眼后果,激发海外与会者的豪放温雅。
该盘问由中山大学附庸肿瘤病院血液肿瘤科主任、博士生导师梁洋素质领衔,其公布的临床数据展现出优异的疗效与安全性,为CLL/SLL 患者带来新的提拔但愿。近日,梁洋素质罗致媒体采访,深度解读了这项盘问的中枢亮点与临床价值。

中山大学附庸肿瘤病院血液肿瘤科主任、博士生导师梁洋素质
新决议破解临床提拔三浩劫题
梁洋素质指出,慢性淋巴细胞白血病(CLL)和小淋巴细胞淋巴瘤(SLL)是吞并疾病的两种发达模式,均属于B细胞非霍奇金淋巴瘤,分裂主要在于病变部位:CLL以骨髓和血液受累为主,SLL则以淋捧场和淋巴组织为主。
“CLL/SLL当作常见的惰性B细胞淋巴瘤,它有两个特质:一是孕育速率慢,另外一个特质瑕瑜常执意,对药物不敏锐。频年来靶向提拔虽获取长足特出,但耐药问题、高危患者提拔疗效欠安以及用药安全性隐患,依然现时 CLL/SLL 提拔中未被得志的中枢需求,尤其是BTK扼制剂提拔失败的复发/难治患者,后续提拔采纳绝顶有限。”梁洋素质指出。
这次亮相好意思国血液学会年会的 mesutoclax 盘问,中枢聚焦于经管 CLL/SLL 提拔中的三浩劫题,为临床提拔提供新决议。最初是攻克耐药贫困,针对复发/难治尤其是 BTK 扼制剂提拔失败的患者,盘问中此类患者的客不雅缓解率(ORR)达到100%,填补了耐药患者的提拔空缺;其次是裁汰提拔风险,盘问选择奥布替尼导入 + mesutoclax 逐步加量的给药神色,凯旋侧目了肿瘤溶化轮廓征(TLS)这一血液肿瘤提拔中的严重并发症,且全程未出现导致停药或死字的不良反映;同期,盘问还追求深度缓解,在终了高缓解率的基础上,显赫普及了患者外周血 65.0%、骨髓53.8%的眇小残留病变阴性(uMRD)率,为患者终了恒久生计奠定基础。
改日获批上市将为患者带来多重积极改换
盘问公布的灵验性数据更是展现出 mesutoclax 的独到提拔后劲。在125毫克剂量组中,UEDBET手机app不管是罗致mesutoclax 皆集奥布替尼提拔的初治CLL/SLL 患者,照旧罗致mesutoclax 单药提拔的复发/难治性患者,客不雅缓解率均达到100%,且这一疗效在BTK扼制剂提拔失败的患者中相通斥地。其中,皆集奥布替尼提拔的患者在 36 周后3个月,外周血眇小残留病变阴性率达到65%,终昭着深度的疾病缓解,彰显出该药物在初治和复发/难治患者中均具备出色的抗肿瘤活性。
安全性是临床用药的蹙迫考量,mesutoclax 在盘问中展现出的精良安全性特征,成为其另一大上风。梁洋素质先容,mesutoclax 单药或与奥布替尼皆集提拔在总共剂量组中,均未不雅察到剂量甘休性毒性(DLT),也未达到最大耐受剂量(MTD),提拔时分出现的不良事件多为1-2 级,患者耐受性高。
慢性淋巴细胞白血病
道及 mesutoclax 改日获批后的临床价值,梁洋素质示意,该药物将为CLL/SLL 患者带来多重积极改换。关于复发/难治尤其是BTK扼制剂提拔失败的患者,mesutoclax 将成为高效的提拔采纳,透彻破解耐药逆境;关于初治患者,能匡助其终了深度疾病缓解,为恒久生计创造要求;同期,其优异的安全性和独到的给药决议,大幅普及患者的提拔体验,为不同病情、不同风险等第的 CLL/SLL 患者提供更优的个体化提拔采纳,举座改善 CLL/SLL 的提拔预后。
当作中国原研的新式BCL2扼制剂,mesutoclax 在ASH 年会上的精彩亮相,不仅展现了中国生物医药在血液肿瘤界限的研发实力,也为各人 CLL/SLL 提拔孝顺了中国决议。跟着后续临床锻练的鼓励,期待 mesutoclax 未必早日获批上市,为更多 CLL/SLL 患者带来新的提拔晨曦,助力普及血液肿瘤的举座提拔水平。
南边+记者 欧旭江uedbet(中国)官方app
米兰app官方网站





 备案号:
备案号: